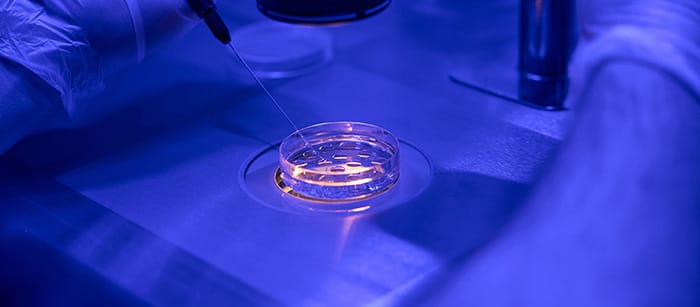
Metode Bayi Tabung ICSI IMSI untuk Meningkatkan Peluang Kehamilan

Bayi tabung atau in vitro fertilization (IVF) merupakan salah satu teknologi reproduksi berbantu di mana proses pembuahan dilakukan di luar tubuh, di dalam cawan laboratorium. Setelah terbentuk, embrio kemudian dipindahkan ke rahim agar dapat berkembang menjadi kehamilan. IVF menjadi solusi bagi pasangan yang mengalami kesulitan memiliki anak karena faktor medis atau kombinasi kondisi pria dan wanita, sekaligus memberikan peluang kehamilan yang lebih terkontrol dan terarah.
Bayi Tabung

Apa Itu IVF (Bayi Tabung)?
Bayi tabung atau In Vitro Fertilization (IVF) adalah metode program kehamilan yang dilakukan dengan cara mempertemukan sel telur dan sperma di luar tubuh, yaitu di laboratorium. Setelah terjadi pembuahan dan terbentuk embrio, embrio tersebut kemudian dipindahkan ke dalam rahim agar dapat berkembang menjadi kehamilan.
Metode ini digunakan untuk membantu pasangan yang mengalami kesulitan memiliki anak, baik karena faktor wanita, pria, maupun kombinasi keduanya. IVF biasanya direkomendasikan ketika metode kehamilan alami atau terapi lainnya belum berhasil. Dengan perkembangan teknologi medis saat ini, bayi tabung menjadi salah satu solusi yang cukup efektif dalam meningkatkan peluang kehamilan.
Tingkat Keberhasilan Bayi Tabung
Tingkat keberhasilan program bayi tabung dapat berbeda pada setiap pasangan, tergantung pada kondisi kesehatan dan faktor lainnya. Mengacu pada standar layanan di klinik fertilitas modern seperti Ciputra IVF, keberhasilan IVF dipengaruhi oleh beberapa faktor utama, antara lain usia wanita, kualitas sel telur dan sperma, serta kondisi rahim.
Secara umum, peluang keberhasilan bayi tabung berkisar antara 30% hingga 60% per siklus. Wanita dengan usia di bawah 35 tahun biasanya memiliki peluang yang lebih tinggi dibandingkan usia yang lebih tua. Selain itu, kondisi kesehatan secara keseluruhan, termasuk gaya hidup dan riwayat medis, juga berperan penting dalam menentukan keberhasilan program ini.
Penggunaan teknologi tambahan seperti ICSI, PGT-A, dan inkubator time-lapse juga dapat membantu meningkatkan peluang keberhasilan dalam kondisi tertentu, tergantung pada kebutuhan masing-masing pasien.
Gambaran Proses Bayi Tabung
Proses bayi tabung dilakukan melalui beberapa tahapan yang terstruktur dan diawasi oleh tenaga medis profesional, yaitu:
- Stimulasi Ovarium
Pasien diberikan terapi hormon untuk merangsang ovarium agar menghasilkan beberapa sel telur dalam satu siklus. - Pengambilan Sel Telur
Sel telur diambil dari ovarium melalui prosedur medis dengan bantuan alat khusus. - Pengambilan dan Persiapan Sperma
Sampel sperma diproses di laboratorium untuk mendapatkan kualitas terbaik. - Pembuahan di Laboratorium
Sel telur dan sperma dipertemukan untuk membentuk embrio. Dalam kondisi tertentu, teknik seperti ICSI dapat digunakan. - Pemantauan Embrio
Embrio dipantau selama beberapa hari untuk melihat perkembangan dan kualitasnya. - Transfer Embrio ke Rahim
Embrio terbaik dimasukkan ke dalam rahim agar dapat berkembang menjadi kehamilan.
Setiap tahap dilakukan dengan pengawasan yang ketat untuk memastikan proses berjalan dengan optimal dan sesuai kondisi pasien.
Layanan Bayi Tabung:
Perawatan kesuburan paling canggih dan efektif yang tersedia saat ini. Proses pembuahan dengan cara mengambil sel telur dan sampel sperma. Kemudian, menggabungkan keduanya secara manual di dalam cawan laboratorium. Lalu, embrio dipindahkan ke dalam rahim agar bisa tubuh dan berkembang.
Artikel Bayi Tabung:
Artikel kesehatan khusus bagi pasangan suami istri yang menginginkan anak. Metode Bayi Tabung menjadi pilihan yang tepat untuk meningkatkan peluang kehamilan Anda, terdapat informasi mengenai Bayi Tabung, definisi, program hingga biaya